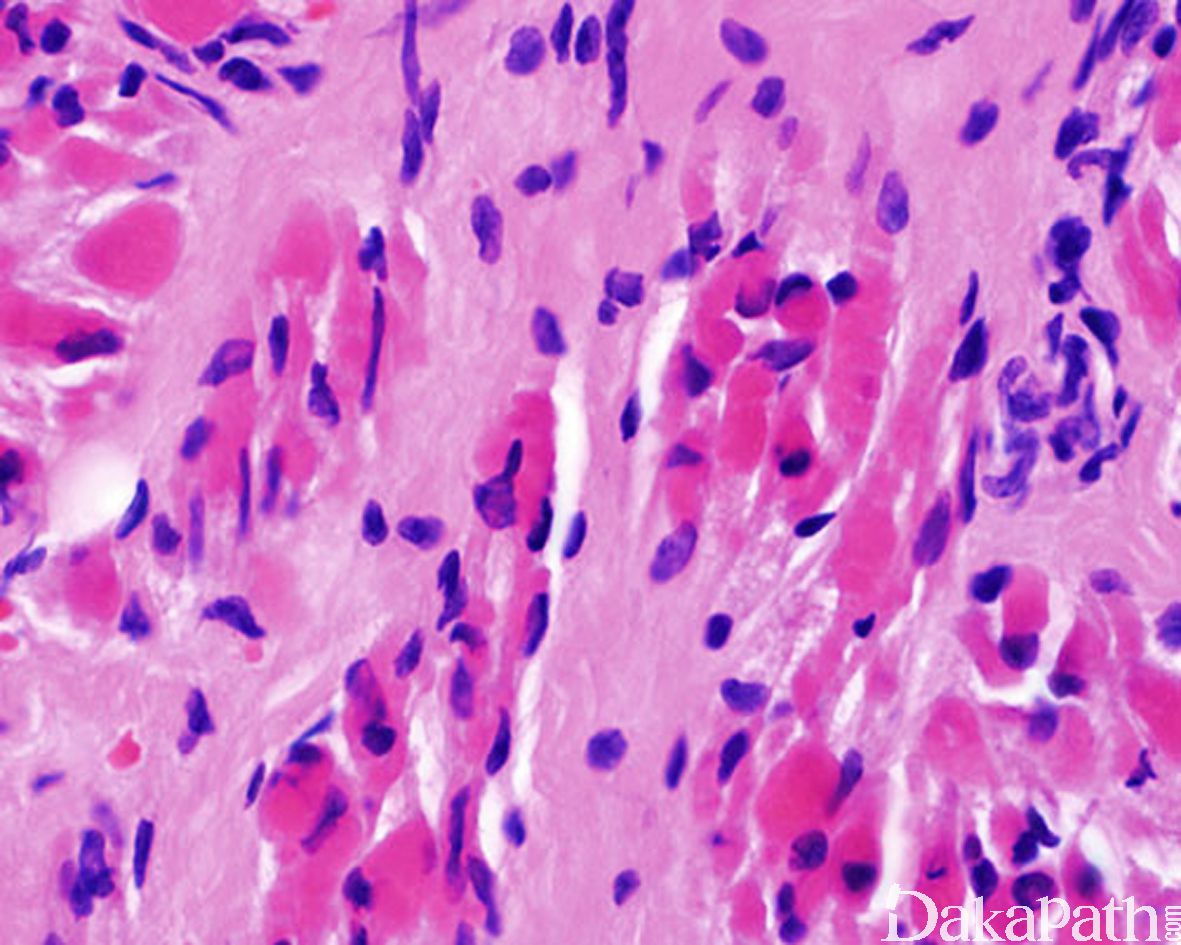

颈纤维瘤病
Fibromatosis Colli
概述:
是一种发生于新生儿胸锁乳突肌内的周界不清的疤痕样肿块,可引起斜颈等不对称性畸形。
发病部位: 主要累及胸锁乳突肌
诊断要点:
- 多发生于新生儿,主要累及胸锁乳突肌的下 1/3,右侧较多见;
- 大体检查于肌肉内可见灰白色的肿块,与周围肌肉组织混杂,周界不清,似疤痕样,质硬;
- 早期胖纤维母细胞、肌纤维母细胞弥漫性增生,排列紊乱,分离横纹肌组织,使之扭曲、变形,间质呈黏液样或胶原化,可见混杂退变的肌巨细胞;
- 晚期细胞数量明显减少,而间质内的胶原纤维大量增加,类似疤痕组织。

免疫组织化学染色:
表达 vimentin,不同程度表达 α-SMA 和 MSA,β-catenin 核阴性。
鉴别诊断:
- 韧带样纤维瘤病 :束状结构更明显,可见纤细的血管,斑驳状肥大细胞浸润,免疫组化染色核表达 b-catenin。
- 增生性肌炎:病程短,一般不发生于胸锁乳突肌,组织学上表现为肥胖的纤维母和肌纤维母细胞,可见慢性炎症、黏液变性、核分裂象以及神经节样细胞。
预后:
90%以上自行退化
治疗:
理疗,极少需要手术
病例报道:
Cytodiagnosis of fibromatosis colli.
Nayak SP, Munshi MM, Bobhate SK.
Cytopathology. 2007 Aug;18(4):266-8. No abstract available.
参考文献:
Sternocleidomastoid tumor of infancy: two cases of an interesting entity.
Jaber MR, Goldsmith AJ.
Int J Pediatr Otorhinolaryngol. 1999 Mar 15;47(3):269-74.
